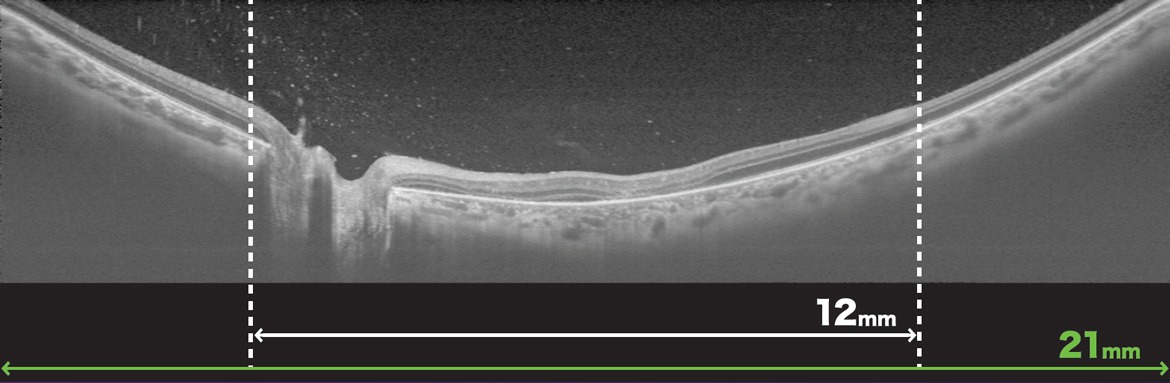

- Diagnostics
- Optical Coherence Tomography (OCT)
DRI OCT Triton series
TOPCONs SS OCT Angio™ combines OCT Angiography with Swept Source OCT technology and a long 1050nm wavelength. OCTARA™, a proprietary image processing algorithm, provides highly sensitive angiographic detection, allowing for visualisation of vascular structures.

Key Features
- High Density Swept Source OCT
- Deep Penetration Including Through Media Opacity
- Multimodal Imaging
- Swept Source OCT Angiography
- Hood Report for Glaucoma
- Wide-Field OCT Max. 21mm Scan
- Wide-Field OCT Angiography
- Smart Denoise
Courtesy: Dr. Yoshinori Mitamura, MD, PhD, Tokushima University, Japan
Gather more clinical insights with wide-field OCT and OCTA imaging is valuable in a wide variety of conditions.

Courtesy: Prof. Christopher Leung, The University of Hong Kong.
High quality OCT and OCT-A images with reduced noise signal are generated from every B-scan
within the dense data cubes, through the use of Topcon’s unique AI algorithm.


Triton’s value in comprehensive eye care settings.

The Hood Report provides Retinal Thickness/ RNFL/ GCL and Circumpapillary Metrics in one scan. This report streamlines the decision-making process through the correlation of structural probability maps (GCC/RNFL) with function (overlay of visual field test locations).

The 12x9mm wide-field scan covers the optic nerve and macula and can be captured in one acquisiton to provide a comprehensive assessment of the posterior pole with reference database comparison.
Note: The information contained on this website is intended for healthcare professionals. Not all products, services, or offers are approved or offered in every market, and products vary from one country to another. Contact your local distributor for country-specific information and availability.